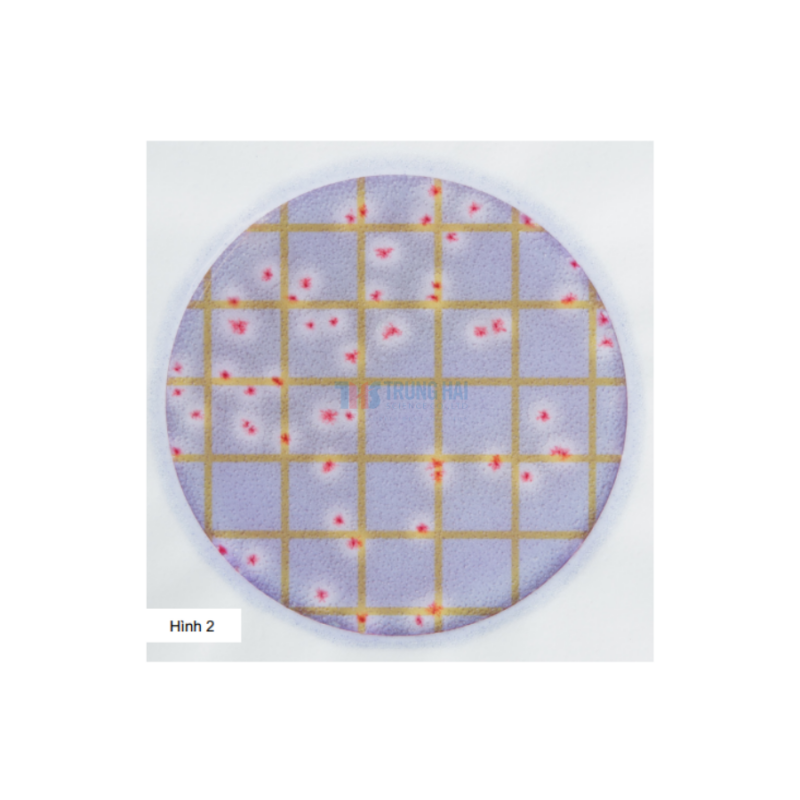
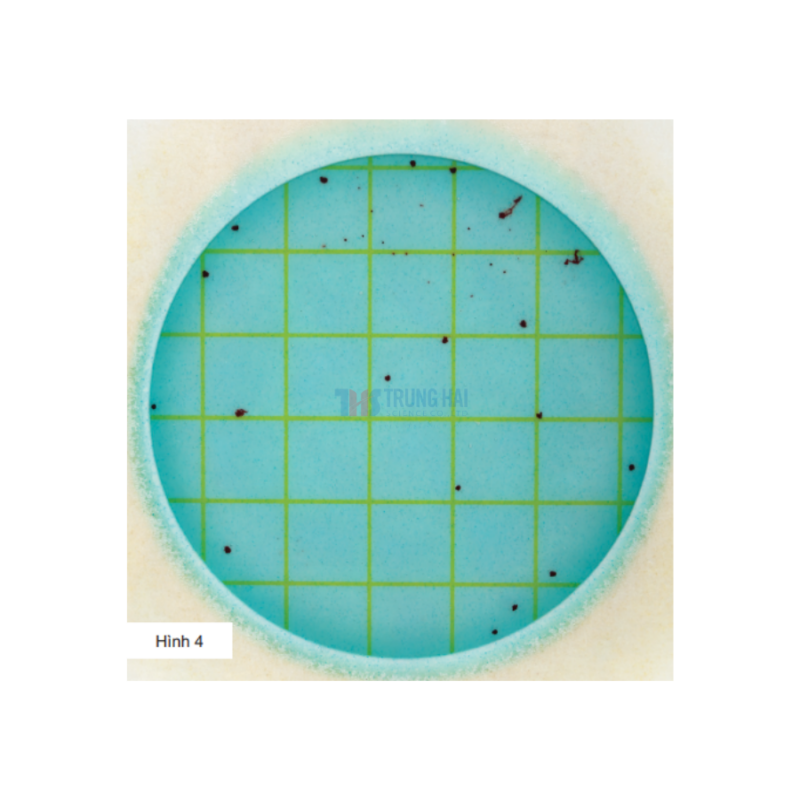

Giải pháp
Danh mục
-
Phân tích Vi sinh vật
- Petrifilm® - Phương pháp phân tích nhanh vi sinh vật
- Hệ thống MDS - Phân tích vi sinh vật gây bệnh
- NCM - Môi trường nuôi cấy vi sinh Neogen
- OBOP-Môi trường vi sinh cải tiến Neogen
- uPREP-Túi môi trường pha sẵn
- Soleris® - Hệ thống phân tích vi sinh vật Realtime thế hệ mới
- Cotitag® - Phân tích E. coli, Coliforms mẫu nước
24.633.000 ₫
✅ AOAC OMA, AOAC PTM, MicroVal
- SKU No. 700006920 | Mã đặt hàng: 6482-6483
- Hãng sản xuất: Neogen
- Đĩa Petrifilm Bacillus cereus giúp kiểm nghiệm nhanh Bacillus cereus trong thực phẩm với thao tác đơn giản, tiết kiệm thời gian và phù hợp cho phòng QC/QA hiện đại.
24.633.000 ₫
✅ AOAC OMA, AOAC PTM, AFNOR NF Validation
- SKU No. 700005496 | Mã đặt hàng: 6478-6479
- Hãng sản xuất: Neogen
- Đĩa Petrifilm kiểm nhanh Tổng khuẩn hiếu khí giúp kiểm nghiệm nhanh vi sinh trong thực phẩm với thao tác đơn giản, tiết kiệm thời gian và phù hợp cho phòng QC/QA hiện đại
24.633.000 ₫
✅ AOAC OMA, AOAC PTM, AFNOR NF Validation
- SKU No. 700002281 | Mã đặt hàng: 6436-6437
- Hãng sản xuất: Neogen
- Đĩa Petrifilm Rapid E. coli/Coliform Count (REC) giúp kiểm nghiệm nhanh Ecoli,Coliform trong thực phẩm với thao tác đơn giản, tiết kiệm thời gian và phù hợp cho phòng QC/QA hiện đại
24.633.000 ₫
✅ AOAC OMA, AFNOR NF Validation, Health Canada MFLP
- SKU No. 700002275 | Mã sản phẩm: 6420-6421
- Hãng sản xuất: Neogen
Đĩa Petrifilm Enterobacteriaceae giúp kiểm nghiệm nhanh Enterobacteriaceae trong thực phẩm với thao tác đơn giản, tiết kiệm thời gian và phù hợp cho phòng QC/QA hiện đại
24.633.000 ₫
- SKU: 700002097 | Mã đặt hàng: SESUP001
- Hãng sản xuất: Neogen
Chất bổ sung SESUP001 - Môi trường chuyên biệt giúp hỗ trợ phục hồi và thúc đẩy sự phát triển của Salmonella trước khi tiến hành phân tích
24.633.000 ₫
- SKU: 700002267 | Mã đặt hàng: SEB500
- Hãng sản xuất: Neogen
Môi trường tăng sinhchuyên biệt dùng để phục hồi và phát triển vi khuẩn Salmonella khi sử dụng cùng đĩa Neogen® Petrifilm® Salmonella Express.
24.633.000 ₫
✅ AOAC OMA, AOAC PTM
- SKU: 700002146 | Mã đặt hàng: 6538-6539
- Hãng sản xuất: Neogen
- Đĩa lồng khẳng đinh Salmonella giúp phòng lab rút ngắn quy trình khẳng định sinh hóa.
24.633.000 ₫
✅ AOAC OMA, AOAC PTM, AFNOR NF Validation, Health Canada MFHPB
- SKU: 700002278 | Mã đặt hàng: 6410-6416
- Hãng sản xuất: Neogen
Đĩa Petrifilm Coliform Count Plates giúp kiểm nghiệm nhanh Coliform trong thực phẩm với thao tác đơn giản, tiết kiệm thời gian và phù hợp cho phòng QC/QA hiện đại
24.633.000 ₫
✅ AOAC PTM, AFNOR NF Validation
- SKU No. 700002228 | Mã đặt hàng: 6461-6462
- Hãng sản xuất: Neogen
Đĩa Petrifilm Lactic Acid Bacteria Count giúp kiểm nghiệm nhanh men mốc trong thực phẩm với thao tác đơn giản, tiết kiệm thời gian và phù hợp cho phòng QC/QA hiện đại.
24.633.000 ₫
✅ AOAC OMA, AFNOR NF Validation, Health Canada MFLP
- SKU No. 700002230 | Mã đặt hàng: 6490-6491
- Hãng sản xuất: Neogen
- Đĩa Petrifilm Staphylococcus aureus giúp kiểm nghiệm nhanh Staphylococcus aureus trong thực phẩm với thao tác đơn giản, tiết kiệm thời gian và phù hợp cho phòng QC/QA hiện đại
24.633.000 ₫
✅ AOAC OMA, Health Canada MFHPB
- SKU No. 700002121 | Mã đặt hàng: 6407-6417
- Hãng sản xuất: Neogen
- Đĩa Petrifilm Yeast & Mold Count Plates giúp kiểm nghiệm nhanh men mốc trong thực phẩm với thao tác đơn giản, tiết kiệm thời gian và phù hợp cho phòng QC/QA hiện đại.
24.633.000 ₫
✅ AOAC PTM, Health Canada
- SKU No. 700002233 | Mã đặt hàng: 6447-6448
- Hãng sản xuất: Neogen
- Đĩa Petrifilm kiểm Listeria môi trường giúp kiểm nghiệm Listeria trong môi trường với thao tác đơn giản, tiết kiệm thời gian và phù hợp cho phòng QC/QA hiện đại